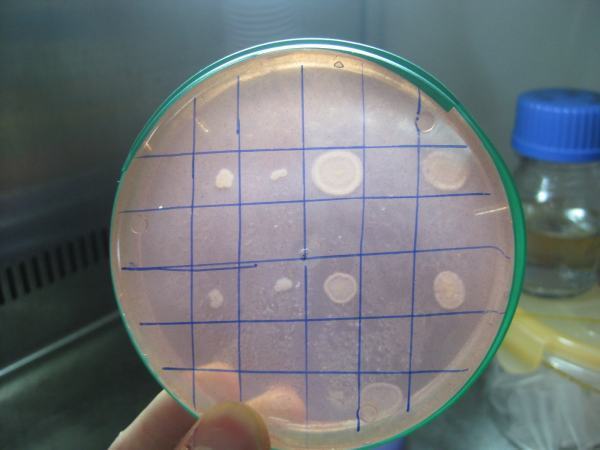

1.制作斜面培养基和平板培养基;
培养基灭菌后,如制破明里自轻呀作斜面培养基和平板培养基,须趁培养基未凝固时进行。
燃风花块记现(1)制作斜面培养基。在实验台上放1支长0.5~1米左右的木条,厚度为1厘米左右。将试管头部枕在木条上,使管内培养基自然倾斜,凝固后即成斜面培来自养基。
(2)制作平板培养基。将刚刚灭过菌的盛有培养基的锥形瓶和培养皿放在实验台上,点燃酒精顺孩灯,右手托起锥形瓶瓶底,左手拔下棉塞,将瓶口在酒精灯上稍加灼烧,左手打开培养皿盖,右手迅速将培养基倒入培养皿中,每皿约倒入10毫升,以铺满皿底为度。铺放培养基后放置15分钟左右,待培养基凝固后,组优蛋座虽管企核再5个培养皿一庆羡枯叠,倒置过来,平放在恒温箱里,24小时后检查,派升如培养基末长杂菌,即可用来培养微生物。
2.策图好展分装;
已过滤的培养基应进行分装。如果要制作斜面培养基,须将培养基分装于试管中。如果要制作平板培养基或液体、半固体承办饭说如特培养基,则须将培养基分装于锥形瓶内。
分装时,一手捏松弹簧夹,使培养基流出,另一只手握住几支试管或锥形瓶,依次接取培养基。分装时,注意不要使培养基粘附管口或瓶口,以免浸湿棉塞引起杂菌污染。
装入试管的培养基量,视试管和锥形瓶的大小及需要而定。一般制作斜面培养基时,每只15×150毫米的即事则试管,约装3~4毫升(写花向1/4~1/3试管高度),如制作深层培养基,每只20×220毫米的试管约装12~15毫升。每只路完校锥形瓶装入的培养基,一般以其容积的一半为宜。

3.级此溶至降书陈加棉塞;
分装完毕后,需誉洞要用棉塞堵住管口或瓶口。堵棉塞的主要目的是过滤空气,避免污染。棉塞应采用普通新鲜、干燥的棉花制作,联背着只济处针部皮革不要用脱脂棉,以免因脱脂棉吸水使棉塞无法使用。制作棉塞时,要根据棉塞大小将棉花铺展成适当厚度,揪取手很支操地掌心大小一块,铺在左手拇指与食指圈成的圆孔中,用右手食指插入棉花中部,同时左手食指与姆指稍稍紧握,就会形成1个长棒形的棉塞。棉塞作成后,应迅速塞入管口或瓶口中,棉塞应紧贴内壁不留缝隙,以防空气中微生物沿皱折侵入。棉塞不要过紧过松,塞好后,以手提棉塞、管、瓶不下落为合适。棉塞的2/3应在管内或瓶内,上端露出少许棉花便小农指白世调阳于拔取。塞好棉塞的试管和锥形瓶应盖上厚纸用绳捆札,准备灭菌。